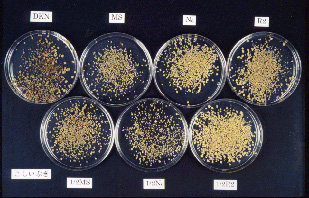

[要約]
水稲品種「こしいぶき」の種子からのカルス誘導、懸濁培養による大量増殖、植物体再分化を効率良く行うことができる。
| [キーワード] | 水稲、こしいぶき、カルス誘導、懸濁培養、大量増殖、植物体再分化 |
| [担当] | 新潟農総研・バイオ研究部 |
| [連絡先] | 0258-35-0047 |
| [区分] | 関東東海北陸農業・北陸・生物工学 |
| [分類] | 科学・普及 |
[背景・ねらい]
水稲品種「こしいぶき」は、品質・食味がコシヒカリ並に優れる早生種であるため、品種改良のための育種素材としても有用である。そこで、本品種を材料に用いたバイオテクノロジーによるイネの品種改良を効率化するため、「こしいぶき」の細胞培養技術を開発する。
[成果の内容・特徴]
[成果の活用面・留意点]
[具体的データ]


図1 こしいぶきの種子カルス(MS培地)
図2 懸濁培養効率に及ぼす基本培地の影響

図3 カルスからの植物体再分化

[その他]
| 研究課題名 | :水稲新品種育成のための花粉培養法の確立 |
| 予算区分 | :県単特別 |
| 研究期間 | :1996~2000年度 |
| 研究担当者 | :大源正明、橋本憲明、星洋介、水野麻里 |
| 発表論文等 | :なし |